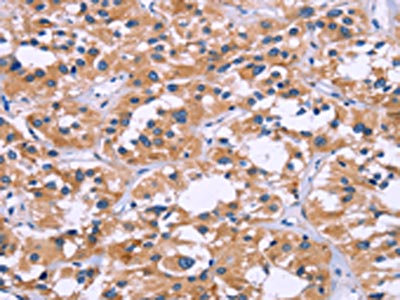

ZEB2 Antibody
-
中文名稱:ZEB2兔多克隆抗體
-
貨號:CSB-PA073575
-
規(guī)格:¥1100
-
圖片:
-
The image on the left is immunohistochemistry of paraffin-embedded Human thyroid cancer tissue using CSB-PA073575(ZEB2 Antibody) at dilution 1/60, on the right is treated with fusion protein. (Original magnification: ×200)
-
The image on the left is immunohistochemistry of paraffin-embedded Human breast cancer tissue using CSB-PA073575(ZEB2 Antibody) at dilution 1/60, on the right is treated with fusion protein. (Original magnification: ×200)
-
-
其他:
產(chǎn)品詳情
-
Uniprot No.:
-
基因名:ZEB2
-
別名:FLJ42816 antibody; HSPC082 antibody; KIAA0569 antibody; SIP 1 antibody; SIP1 antibody; Smad Interacting Protein 1 antibody; Smad-interacting protein 1 antibody; SMADIP 1 antibody; SMADIP1 antibody; ZEB 2 antibody; Zeb2 antibody; ZEB2_HUMAN antibody; Zfhx1b antibody; ZFHX1B protein antibody; Zfx1b antibody; Zinc finger E box binding protein 2 antibody; Zinc finger E-box-binding homeobox 2 antibody; Zinc finger homeobox 1b antibody; zinc finger homeobox protein 1 antibody; Zinc finger homeobox protein 1b antibody
-
宿主:Rabbit
-
反應種屬:Human,Mouse
-
免疫原:Fusion protein of Human ZEB2
-
免疫原種屬:Homo sapiens (Human)
-
標記方式:Non-conjugated
-
抗體亞型:IgG
-
純化方式:Antigen affinity purification
-
濃度:It differs from different batches. Please contact us to confirm it.
-
保存緩沖液:-20°C, pH7.4 PBS, 0.05% NaN3, 40% Glycerol
-
產(chǎn)品提供形式:Liquid
-
應用范圍:ELISA,IHC
-
推薦稀釋比:
Application Recommended Dilution ELISA 1:2000-1:5000 IHC 1:50-1:200 -
Protocols:
-
儲存條件:Upon receipt, store at -20°C or -80°C. Avoid repeated freeze.
-
貨期:Basically, we can dispatch the products out in 1-3 working days after receiving your orders. Delivery time maybe differs from different purchasing way or location, please kindly consult your local distributors for specific delivery time.
-
用途:For Research Use Only. Not for use in diagnostic or therapeutic procedures.
相關(guān)產(chǎn)品
靶點詳情
-
功能:Transcriptional inhibitor that binds to DNA sequence 5'-CACCT-3' in different promoters. Represses transcription of E-cadherin. Represses expression of MEOX2.
-
基因功能參考文獻:
- ZEB2 expression is resulting in drastic changes at the chromatin level with both clear DNA hypermethylation and histone modifications.ZEB2 directly binds to E-box sequences in the RAB25 promoter. PMID: 30445998
- NORAD could serve as a ceRNA in cervical cancer progression by modulating miR-590-3p/SIP1 axis. PMID: 30119219
- Study shows that ZEB2 negatively regulates a GalNAc-transferase (GALNT3) that is involved in O-glycosylation adds another layer of complexity to the role of ZEB2 in cancer progression and metastasis. PMID: 29516288
- Mutations in SIP1 gene are responsible for absence of its expression in Hirschsprung's disease. PMID: 29600337
- Data identified SIP1 as a direct target of mir-145, and its expression was suppressed both at mRNA and protein levels in colorectal neoplasm mediating cancer cell proliferation, migration and invasion. PMID: 28833449
- miR-146a promoted hepatitis b virus replication by targeting ZEB2. PMID: 29902868
- ZEB2 attenuated LPS-induced inflammation cytokine secretion possibly through suppressing the NF-kappaB signaling pathway PMID: 29318479
- The percentages of ZEB1 high expression and ZEB2 high expression were 31.9% (29/91) and 41.9% (36/91), respectively. High expression of ZEB2 was significantly associated with lower survival rate of GBM patients (P=0.001). PMID: 29476046
- Results suggest that Src promotes EGF-stimulated EMT and migration by upregulation of ZEB1 and ZEB2 through AKT signaling pathway in gastric cancer cells. PMID: 29052277
- miR-192 was a critical factor of HS formation and facilitated skin fibrosis by targeting directly SIP1. PMID: 28884252
- Results show that ZEB2 is highly expressed in small cell lung cancer (SCLC) tissue samples and consistent with E2F1 expression. Also, further data showed that E2F1 regulated ZEB2 expression through E2F1 binding sites on the promoter of ZEB2 in SCLC. PMID: 29115924
- Our study confirms that the two susceptibility loci ZFHX1B and SNTB1 are associated with moderate to high myopia in a Han Chinese population, as well as in a European population, when both SNPs are combined. PMID: 28848321
- High expression of ZEB2 is associated with drug resistance in gastric cancer. PMID: 28534959
- The present study validated the prognostic value and clinicopathological association of ZEB1 and ZEB2 in digestive cancers, especially in gastric cancer. PMID: 28416756
- ZEB2 suppress apoptosis of vascular endothelial cells induced by high glucose through MAPK pathway activation, which provides a novel insight and therapeutic target for endothelial injury. PMID: 28551696
- Study found SIP1 expression was up-regulated and closely related to diminished survival in intrahepatic cholangiocarcinoma (ICC) patients. It is the direct and functional target of miR-590-3p in ICC cells. PMID: 28423728
- miR-30a-5p directly targeted the 3'-UTR of ZEB2 and suppressed clear cell renal cell epithelial-mesenchymal transition. PMID: 28569782
- Our data demonstrate a directly negative feedback loop between miR-203 and ZEB2 participating in tumor stemness and chemotherapy resistance in nasopharyngeal carcinoma PMID: 27589832
- ZEB2 expression was higher in HCC tissues and was negatively related to miR-211-5p levels. PMID: 28437884
- Study shows that ZEB2 expression is controlled at protein synthesis level in cancer cells. Authors propose that the underlying mechanism represents a novel regulatory scheme based on ribosome pausing and degradation of the nascent peptide. PMID: 28783176
- Simultaneous knockdown of both ZEB1 and ZEB2 expression establishes ZEB1 as a transcriptional repressor of E-cadherin and a driver of docetaxel resistance in docetaxel-resistant prostate cancer cells. PMID: 28133913
- Study demonstrate that CdGAP acts as a novel co-transcriptional repressor with Zeb2 to suppress E-cadherin expression in breast cancer cells. PMID: 28135249
- siRNAs targeting Ets1 repressed expression of ZEB1/ZEB2. PMID: 28247944
- overexpression of miR-218 in H1299 increased chemosensitivity of cells to cisplatin treatment through suppression of Slug and ZEB2. These findings highlight an important role of miR-218 in the regulation of EMT-related traits and metastasis of lung cancer in part by modulation of Slug/ZEB2 signaling, and provide a potential therapeutic strategy by targeting miR-218 in lung cancer. PMID: 28192397
- results revealed the critical regulatory role of miR-145 in hepatic stellates cells activation and implied miR-145 as a potential candidate for therapy of hepatic fibrosis by regulation of Wnt/beta-catenin through targeting ZEB2 PMID: 27289031
- Results show that inhibition of miR-141 enhanced colorectal cancer (CRC) cell proliferation and migration through significant increase of its target's expression, ZEB2 and phosphorylation of HGFR. PMID: 28739727
- This Gene-based tests suggest evidence of association with related genes, ZEB2, RND3, MCTP1, CTBP2, and beta EEG. PMID: 28040410
- Collectively, the results demonstrate that Zeb2 controls adult hematopoietic differentiation and lineage fidelity through widespread modulation of dominant signaling pathways that may contribute to blood disorders. PMID: 27683414
- ZEB2 transcriptionally represses genes that regulate myeloid differentiation, including genes involved in cell adhesion and migration; epigenetic silencing of the miR-200 family microRNAs affects ZEB2 expression. PMID: 27756750
- This study identified the lysine-specific demethylase KDM1A as a novel interaction partner of ZEB2 and demonstrated that mouse and human T-cell acute lymphoblastic leukemia cells with increased ZEB2 levels critically depend on KDM1A activity for survival. PMID: 28069602
- e revealed there was a reciprocal repression between MALAT1 and miR-204. ZEB2 was identified as a downstream target of miR-204 and MALAT1 exerted its function mainly through the miR-204/ZEB2 axis. Our findings suggested that MALAT1 may serve as a new diagnostic biomarker and therapy target for breast cancer. PMID: 28675122
- This locus harbors an evolutionary conserved gene-desert region with non-coding intergenic sequences likely involved in regulation of protein-coding flanking genes ZEB2 and ACVR2A. This region is intensively studied for mutations causing severe developmental/genetic disorders. Our analyses indicate a promising target region for interventions aimed to reduce risks of many major human diseases and mortality. PMID: 27832070
- low miR-145 expression levels in conjunction with elevated SIP1 expression levels may contribute to cervical cancer development. PMID: 27933466
- Knockdown of ZEB2 can inhibit HOXB8-induced migration and invasion capacity, as well as the epithelial-mesenchymal transformation in gastric cancer cells. The results showed that HOXB8 plays an important role in the development and metastasis of gastric carcinoma PMID: 27761656
- results highlight a feedback loop between miR-203 and ZEB2, which participates in the pathogenesis of lung adenocarcinoma PMID: 27733346
- This is the first study claiming the association of the genetic risks of rs6755392 in the ZEB2 gene with schizophrenia. PMID: 26654950
- Report of the first confirmed cases of Mowat Wilson syndrome in three children with the typical facial features, mental retardation, absent corpus callosum, epilepsy, and Hirschsprung's disease and novel Zeb2 variations on DNA analysis. PMID: 26852091
- Bioinformatics analyses showed that miR-138 targeted the 3'-UTR of ZEB2 mRNA to inhibit its translation. Furthermore, miR-138 overexpression inhibited ZEB2-mediated cell invasion and metastases, while miR-138 depletion increased ZEB2-mediated cell invasion and metastases in BC cells PMID: 26646296
- restoration of ZEB2 effectively reversed the Reduced expression of ZEB2, as well as the suppressive effects of miR200b overexpression on the proliferation. PMID: 26648487
- High ZEB2 expression is associated with clear cell kidney carcinoma. PMID: 26461224
- Results establish that the dowregulation of GADD45G-SIP1 axis may contribute to cellular senescence evasion and HCC development. PMID: 26378039
- restoration of expression of ZEB2 weakened miR-154-mediated suppression of tumor progression. miR-154 functions as a tumor suppressor in HCC by suppressing ZEB2, suggesting that miR-154 may serve as a potential target for HCC. PMID: 26503460
- suggest that deltaEF1 family proteins promote cell motility of breast cancer cells directly or indirectly through repressing expression of RGS16 PMID: 26823172
- nuclear ZEB2 may enhance progression of EMT transition and acquisition of an aggressive phenotype in ovarian cancer PMID: 26136338
- In gastric tumor samples the expression levels of ZEB2 were inversely correlated with the expression of miR141. PMID: 25975736
- This work provides a plausible mechanism for inflammation-induced metastatic potential in TNBC, involving a novel regulatory mechanism governing ZEB2 isoform expression. PMID: 25762639
- Findings reveal that miR-200a suppresses metastasis of SP cells by downregulating ZEB2. PMID: 25797260
- This review introduces Zeb2 as an essential regulator of nervous system development. PMID: 26193487
- co-expression of TWIST1 and ZEB2 in OSCC was significantly associated with poorer overall survival, particularly in patients without detectable lymph node metastasis. PMID: 26214683
- Our study first indicates that miR-590-3p functions as a suppressor of GBM EMT and metastasis by targeting ZEB1 and ZEB2, and it may be a therapeutic target for metastatic GBM. PMID: 26556542
顯示更多
收起更多
-
相關(guān)疾?。?/div>Mowat-Wilson syndrome (MOWS)亞細胞定位:Nucleus. Chromosome.蛋白家族:Delta-EF1/ZFH-1 C2H2-type zinc-finger family數(shù)據(jù)庫鏈接:
Most popular with customers
-
-
Phospho-YAP1 (S127) Recombinant Monoclonal Antibody
Applications: ELISA, WB, IHC
Species Reactivity: Human
-
-
-
-
-
-